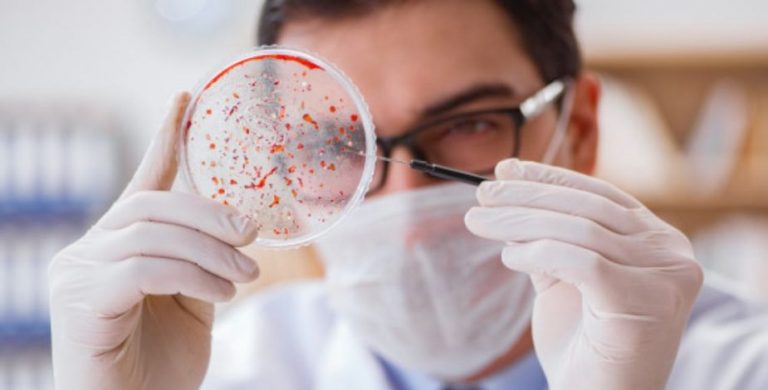
cifras covid al 5 de julio

Durante la mañana de este domingo 5 de julio, el Ministerio de Salud entregó el último balance respecto al avance del Covid-19 en Chile.
En palabras de las autoridades, se reportaron 3.685 nuevos casos, llegando así a un total de 295.532 contagiados desde el inicio de la pandemia en el país. De los diagnósticos nuevos, contabilizados hasta las 21 hrs. de ayer sábado, 2.852 presentaron síntomas.
Te puede interesar: #CONCURSO ¡El vinilo «Foo Fighters», a 25 años de su lanzamiento, puede ser tuyo!
Con respecto a los fallecidos, este 5 de julio se informaron 116 víctimas fatales, llegando a un total de acuerdo a los datos entregados por el Minsal de 6.308.
Cabe recordar, que durante el balance del viernes, el Jefe de Epidemiología del Ministerio de Salud, Rafael Araos, indicó que las cifras diarias de fallecidos deben considerarse «tendencia», ya que es el número de fallecidos, confirmado por el Departamento de Estadísticas e Información de Salud (DEIS), los que corresponden a una cifra más real. Esto, ya que esta última cifra corresponde al resultado de una revisión con distintas bases de datos y con más tiempo de análisis que las cifras diarias.
La cifra del DEIS, que hasta el 30 de junio de 2020 informaba 6.554 fallecidos por Covid-19 en Chile, "es el número que debe ser tomado para cualquier análisis y proyección", dijo Araos.
En cuanto a las Redes Asistenciales, este 5 de julio se reportaron 2.078 personas en Unidades de Cuidados Intensivos, de los cuales 385 están en estado crítico. Además, hay 350 ventiladores disponibles.
Revisa el detalle por regiones al 4 de julio a las 21 hrs.:

Por último, se tomaron 18.004 exámenes realizados en las últimas 24 horas.
Recuerda que puedes revisar más cifras y gráficos oficiales en www.gob.cl/coronavirus.
Sigue a Rockandpop.cl en Google Discover
Recibe nuestros contenidos directamente en tu feed.